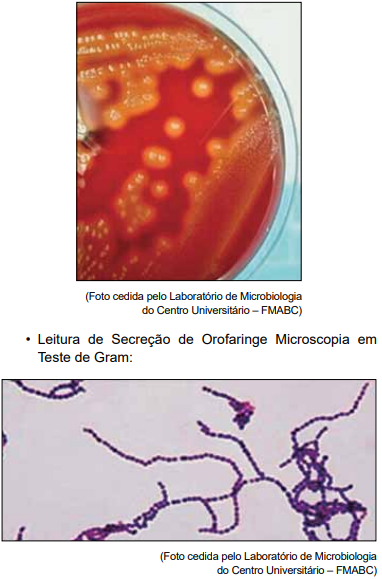
Enunciado 4730380-1

Foram encontradas 785 questões.
No setor de Hematologia do Laboratório de Análises
Clínicas do LABFMABC, o plantão recebeu um tubo
de sangue total, realizou o processamento desse hemograma e a extensão sanguínea.
Nessa lâmina observou-se a imagem a seguir:

A imagem observada corresponde a:
Nessa lâmina observou-se a imagem a seguir:

A imagem observada corresponde a:
Provas
Questão presente nas seguintes provas
Na microscopia de um protoparasitológico (1a amostra) foi encontrada a seguinte estrutura demonstrada a seguir:

A identificação desse ovo refere-se ao seguinte agente etiológico:
Provas
Questão presente nas seguintes provas
A ordem correta para venopunção por tubos a vácuo para
evitar a contaminação por aditivos, segundo a Sociedade
Brasileira de Patologia Clínica, é:
Provas
Questão presente nas seguintes provas
Paciente masculino, de 63 anos de idade, confirmou
resultado positivo para o Teste de covid-19 no exame
de Biologia Molecular. Além do teste de covid-19 foi realizado uma gasometria arterial que demonstrou o seguinte
resultado:

Avaliando o resultado da gasometria arterial, o quadro em que o paciente se encontra é de:

Avaliando o resultado da gasometria arterial, o quadro em que o paciente se encontra é de:
Provas
Questão presente nas seguintes provas
O desempenho de um teste diagnóstico é frequentemente
expresso em termos de sensibilidade e especificidade, e
outros indicadores, em comparação com o Padrão Ouro.
Sobre os indicadores utilizados nos testes diagnósticos, assinale a alternativa correta.
Sobre os indicadores utilizados nos testes diagnósticos, assinale a alternativa correta.
Provas
Questão presente nas seguintes provas
Qual é o exame utilizado para detecção de Mycobacterium tuberculosis, que possui sensibilidade muito superior
à baciloscopia clássica e vantagens com relação à cultura,
com rapidez (resultado em poucas horas) e que verifica a
resistência à rifampicina, droga chave no tratamento desta
infecção?
Provas
Questão presente nas seguintes provas
Adolescente de 17 anos deu entrada no Hospital Municipal da Barra Funda com os seguintes sintomas: febre,
palpitações no coração e pequenas erupções cutâneas,
sendo internado. Esse paciente, há um mês, esteve nesse
mesmo hospital, diagnosticado com faringoamigdalite e foi
prescrito o uso de antibioticoterapia de uso oral. Todavia, o
paciente relatou que interrompeu o uso do antibiótico por
conta própria.
Foram realizados os seguintes exames:
• Antiestreptolosina O (ASLO) Resultado: 515 UI/M Valor de referência: Inferior a 200 UI/m
• Proteína C Reativa Resultado: 14,0 mg/dL Valor de referência: Indicador de processos infecciosos e/ou inflamatórios.
De 1,0 a 5,0 mg/dL: encontrado em infecções virais e processos inflamatórios leves.
De 5,1 a 20,0 mg/dL: encontrado em infecções bacterianas e processos inflamatórios sistêmicos.
Acima de 20,0 mg/dL: encontrado em infecções graves, grandes queimados e em politraumatismo.
• Leitura de Secreção de Orofaringe Macroscopia em meio a cultura Ágar sangue:

• Resultado do Teste de Catalase: Negativo.

De acordo com os resultados apresentados nos exames laboratoriais e realizando a interpretação laboratorial das imagens observadas, o agente etiológico presente na amostra de secreção de orofaringe do paciente em questão pode ser identificado como:
Foram realizados os seguintes exames:
• Antiestreptolosina O (ASLO) Resultado: 515 UI/M Valor de referência: Inferior a 200 UI/m
• Proteína C Reativa Resultado: 14,0 mg/dL Valor de referência: Indicador de processos infecciosos e/ou inflamatórios.
De 1,0 a 5,0 mg/dL: encontrado em infecções virais e processos inflamatórios leves.
De 5,1 a 20,0 mg/dL: encontrado em infecções bacterianas e processos inflamatórios sistêmicos.
Acima de 20,0 mg/dL: encontrado em infecções graves, grandes queimados e em politraumatismo.
• Leitura de Secreção de Orofaringe Macroscopia em meio a cultura Ágar sangue:
• Resultado do Teste de Catalase: Negativo.

De acordo com os resultados apresentados nos exames laboratoriais e realizando a interpretação laboratorial das imagens observadas, o agente etiológico presente na amostra de secreção de orofaringe do paciente em questão pode ser identificado como:
Provas
Questão presente nas seguintes provas
Uma das políticas de saúde relacionadas à nutrição é a
Política Nacional de Suplementação de Ferro, instituída
pelo Ministério da Saúde em 2005. Um dos públicos-alvo
desse programa são
Provas
Questão presente nas seguintes provas
A Política Nacional de Alimentação e Nutrição (PNAN) é
parte integrante da Política Nacional de Saúde e dedicou
à população brasileira o Guia Alimentar, que foi revisto
recentemente (2014). Entretanto, suas bases se mantêm
e reforçam a ideia de que
Provas
Questão presente nas seguintes provas
Os pontos de corte adotados e orientados pelo Sistema
de Vigilância Alimentar e Nutricional para a avaliação do
estado nutricional de adolescentes utiliza parâmetros que
combinam dados de
Provas
Questão presente nas seguintes provas
Cadernos
Caderno Container